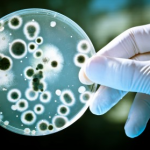
Bakteri Super Kebal Antibiotik, Apa Itu? dan Haruskah Anda Panik?

Artikel Pilihan di Bulan Mei 2016
Editorial
Halo farmasetikers!
Selamat datang di majalah farmasetika. Majalah farmasi online pertama di Indonesia.
Di edisi ini, farmasetika.com memperbarui visi dan misinya sebagai situs penyedia informasi farmasi terkini berbasis ilmiah dan praktis yang ditandai dengan peluncuran logo baru di awal bulan Mei lalu. Selain itu, bagian editorial memberikan informasi dengan judul "Editorial : Farmasetika.com Satu-satunya Situs Kefarmasian di Berita Google".
Untuk topik dispensing diisi beberapa artikel yang menarik untuk dibaca, seperti "Bakteri Super Kebal Antibiotik yang Ditakutkan Para Ahli Kini Hadir Di Amerika", "Apoteker Mulai Bisa Mengganti Obat yang Diresepkan di Arizona","Kelebihan Dosis Obat Antidiare Loperamid Bisa Sebabkan Aritmia Jantung Fatal",dan "5 Terapi Migrain Tanpa Konsumsi Obat Menurut Apoteker".
Dibagian sediaan farmasi dan farmasi industri diantaranya "Roche Luncurkan Alat Pengecekan Antikoagulan Berteknologi Bluetooth", "Obat Baru Insulin Degludec Bisa Bekerja 42 Jam dengan Waktu Pemberian Berbeda", dan "Tahapan Proses Produksi Vaksin di Bio Farma yang Berkualitas Dunia".
Topik R&D dan regulasi di bulan Mei ini banyak artikel yang wajib untuk dibaca seperti "7 Mekanisme Obat Baru Untuk Terapi Kanker Paling Efektif di Masa Depan" , "BPOM Keluarkan Pedoman Pengelolaan Obat Tertentu yang Sering Disalahgunakan" , dan "FDA Peringatkan Ketokonazol Tablet Bisa Sebabkan Kerusakan Hati Serius".
Semoga bermanfaat!
Pimpinan redaksi,
Nasrul Wathoni, Ph.D., Apt
Info Farmasi Terkini Berbasis Ilmiah dan Praktis Majalah Farmasi Online Pertama di Indonesia